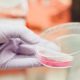

Benign Prostatic Hyperplasia (BPH)
Prostate Cancer
April 2, 2021
Prostate Cancer
May 4, 2021Benign Prostatic Hyperplasia (BPH)
What Is Benign Prostatic Hyperplasia (BPH)?
Benign Prostatic Hyperplasia (BPH) – enlargement of prostate - is a non-cancerous condition that is common as men get older. An enlarged prostate can cause difficulties in urination such as poor flow, hesitancy (start/stop) and frequency in urination. In severe cases, men are unable to pass urine at all.
There are several ways to treat BPH including lifestyle changes, medication, minimally invasive therapy or surgery. Speak to your urologist to discuss which option is most suitable for you.
Symptoms of Benign Prostatic Hyperplasia (BPH)
Common symptoms that you may experience may include the following:
- Frequent or urgent need to urinate
- Increased frequency of urination at night (nocturia)
- Difficulty starting urination
- Weak urine stream or a stream that stops and starts
- Dribbling at the end of urination
- Inability to completely empty the bladder
The size of your prostate might not have direct link to the severity of your symptoms. For example: you can have a mildly enlarged prostate but severe symptoms, similarly, you can have severely enlarged prostate with minimal symptoms.
Diagnosis of Benign Prostatic Hyperplasia (BPH)
Digital Rectal Examination (DRE): The doctor will need to examine the prostate by inserting a finger into the back passage. It is uncomfortable but not painful. It is important to ensure there are no hard nodules in prostate which might be a sign of prostate cancer.
Ultrasound Scan: An ultrasound scan will usually be performed to determine the size of the prostate and degree of protrusion into bladder. The scan will also tell us if urine is trapped within the bladder, ureters or kidneys.
Uroflow: You will need to perform a uroflow test by passing urine into a machine. The machine will analyse if there are any concerns with your bladder capacity and flow.
Prostate Specific Antigen (PSA): Prostate cancer can co-exist with BPH. This blood test helps the doctor to differentiate between the two.
Treatment of Benign Prostatic Hyperplasia (BPH)
Treatment depends on the severity of your symptoms and the size of your prostate.
- Lifestyle modification
- Medication
- Flexible cystoscopy
- Urodynamic Study
- TURP (Transurethral Resection of Prostate)
- TUERP (Transurethral Enucleation of Prostate)
- Laser prostate surgeries
- Minimal invasive BPH treatment: Prolieve Microwave Thermodilation
- Permanent Urethral Stents
Complications of Benign Prostatic Hyperplasia (BPH)
If left untreated, BPH can cause complications as a result of not being able to pass urine properly.
- Unable to pass urine
- Recurrent urinary tract infection
- Bladder Stones
- Overdistended bladder
- Kidney Infection and damage



